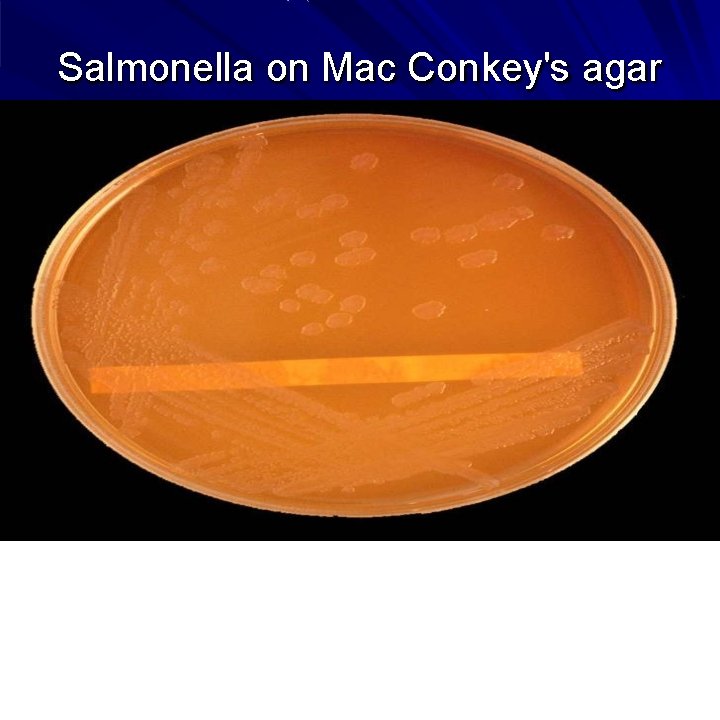
Salmonella on Mac Conkey's agar

TYPHOID DR SUDHANSHU MISHRA Asst Professor Community Medicine




























































- Slides: 60

TYPHOID DR SUDHANSHU MISHRA Asst. Professor Community Medicine Department CIMS & H

Typhoid---ancient Greek Typhos, smoke or cloud that was believed to cause disease or madness

What is Typhoid Fever? • Result of systemic infection caused by S. typhi. • Clinically characterized by typical continuous fever for 3 to 4 weeks, relatively bradycardia with involvement of intestinal lymphoid tissues, reticuloendothelial system & gall bladder. • “Enteric fever” includes both typhoid and paratyphoid fever. • May occur sporadically, epidemically or endemically. Found only in human.

FAMOUS HISTORICAL PERSONALITIES Related with TYPHOID

History Antonius Musa, a Roman physician who achieved fame by treating the Emperor Augustus 2, 000 year ago, with cold baths when he fell ill with typhoid. Thomas Willis who is credited with the first description of typhoid fever in 1659.

French physician Pierre Charles Alexandre Louis first proposed the name “typhoid fever” William Wood Gerhard who was the first to differentiate clearly between typhus fever and typhoid in 1837.

Carl Joseph Eberth who discovered the typhoid bacillus in 1880. Georges Widal who described the „Widal agglutination reaction‟ of the blood in 1896.

PROBLEM STATEMENT Typhoid fever

Typhoid fever is prevalent in many regions in the world High endemicity (>100 cases per lac per year) Medium endemicity (10 cases per lac per year) Low endemicity (<10 cases per lac per year)

WHO Estimate Infects roughly 21. 6 million people each year

WHO Estimate Kills 21600000 people each year

WHO Estimate 62% of these occurring in Asia and 35% in Africa

India • World largest outbreak of typhoid in SANGLI on December 1975 to February 1976. This disease is endemic in India • 1992 : 3, 52, 980 cases with 735 deaths • 1993 : 3, 57, 452 cases and 888 deaths • 1994 : 2, 78, 451 cases and 304 deaths • 2011 : 1. 06 million cases & 346 deaths • 2014 : 1. 7 million cases & 429 deaths • Case fatality rate due to typhoid has been varying between 1. 1% to 2. 5 % in last few years. • In south-East Asia 50% or more of the strains of bacteria has MDR

EPIDEMIOLOGICAL DETERMINANTS 1. 2. 3. 4. 5. Agent factors Host factors Environmental & social factors Incubation period Mode of transmission

1 - AGENT FACTORS a- Host • Typhoid Fever mainly caused by the bacterium Salmonella typhi from the family Enterobacteriacea. • S. para A&b are relatively infrequent. • S. typhi is a gram-negative, facultative aerobic, non spore forming bacteria that is motile due to its peritrichous flagella. • The bacteria grows best at 37 C.

Antigenic structure of Salmonella Two sets of antigens Detection by serotyping • 1 Somatic or 0 Antigens contain long chain polysaccharides ( LPS ) comprises of heat stable polysaccharide commonly. • 2 Flagellar or H Antigens are strongly immunogenic and induces antibody formation rapidly and in high titers following infection or immunization. The flagellar antigen is of a dual nature, occurring in one of the two phases.

Color pink therefore Gram-negative With peritrichous flagella

b- Reservoir of infection human is the only reservoir 1. Cases 2. Carriers • A case is infectious as long as bacilli appears in stools or urine. • Case may be missed, mild or severe. • Temporary/incubatoryexcrete bacilli for 6 to 8 weeks • Chronic- excrete bacilli for more than a year, organism persist in gall bladder/biliary tract. e. g. “Typhoid Marry” real name Mary Mallon

M a ry M a llo n (w e a rin g gla sse s) p h o to gra p h e d w ith b a c te riolo gist E m m a S h e rm a n o n N o rth B ro th e r Isla n d in 1 9 3 1 o r 1 9 3 2 , o ve r 1 5 ye a rs a fte r sh e had been q u a ra n tin e d th e re p e rm a ne n tly.

• Mary Mallon was a cook in Oyster Bay, New York in early 1900 s. • Gave rise to more than 1300 cases in her life time. • She died of pneumonia after 26 years in quarantine.

c- Source of infection Primary sources Secondary sources • Faeces & urine of cases and carriers. • Contaminated – Water – Food – Fingers – Flies • Faecal carriers are more frequent than urinary carriers.

How does the bacteria cause disease ?

Ingestion of contaminated food or water Salmonella bacteria Invade small intestine and enter the bloodstream Carried by white blood cells in the liver, spleen, and bone marrow Multiply and reenter the bloodstream Bacteria invade the gallbladder, biliary system, and the lymphatic tissue of the bowel and multiply in high numbers Then pass into the intestinal tract and can be identified for diagnosis in cultures from the stool tested in the laboratory

2 - HOST FACTORS (a)Age- occur at any age but highest incidence in 5 -19 yrs age group. (b) Sex- cases more in Males than Female carrier rate is more in females (c)Immunity- antibody may be stimulated by infection or immunization. Antibody against (O) antigen is higher in patient with the disease and antibody against (H) antigen is higher in immunized person. S. Typhi is intracellular organism so cell mediated immunity plays a major role in combating the infection.

3 - ENVIRONMENTAL & SOCIAL FACTORS Typhoid fever regarded as “Index of general sanitation” in any country. Increase incidence in July-September. Outside human body bacilli found inwater- 2 to 7 days but not multiply soil irrigated with sewage- 35 to 70 days ice & icecream- over a month food- multiply & survive for sometime milk- grow rapidly without altering its taste Vegetables grow in sewage plant. Pollution of drinking water supplies. Open area defecation & urination. Low personal hygiene. Health ignorance.

4 - INCUBATION PERIOD Usually 10 -14 days but it may be as short as 3 days or as long as 21 days depending upon the dose of the bacilli ingested.

5 - MODE OF TRANSMISSION The disease is transmitted by “faeco-oral route” or “urine–oral routes” either directly through hands soiled with faeces or urine of cases or carriers or indirectly by ingestion of contaminated water, milk, food, or through flies. Contaminated ice, ice-creams, and milk products are a rich source of infection. water Faeces and urine from cases or carriers soil flies fingers Foods raw or cooked Mouth of well persons

CLINICAL FEATURES • First week: malaise, headache, cough & sore throat in prodromal stage. The disease classically presents with step-ladder fashion rise in temperature (40 - 41°C) over 4 to 5 days, accompanied by headache, vague abdominal pain, and constipation or pea soup Diarrhoea. • Second week: Between the 7 th -10 th day of illness, mild hepatosplenomegally occurs in majority of patients. Relative bradycardia may occur and rose-spots may be seen. • Third week: The patient will appear in the "typhoid state" which is a state of prolonged apathy, toxemia, delirium, disorientation and/or coma. Diarrhoea will then become apparent. If left untreated by this time, there is a high risk (5 -10%) of intestinal hemorrhage and perforation. • Rare complications: Hepatitis, Pneumonia, Thrombophlebitis, Myocarditis, Cholecystitis, Nephritis, Osteomyelitis, and Psychosis. 2 -5% patients may become Gall-bladder carriers

Rose spots Pink papule 2 -3 mm on trunk, fade on pressure Disappears in 3 -4 days

SIGNS & SYMPTOMS Rose spots Aches and pains Diarrhoea Chest congestion High fever Typhoid Meningitis

GENERAL COMPLICATIONS

MEDICAL COMPLICATIONS

MAJOR SURGICAL COMPLICATIONS

PATIENT PERFORATION

MAJOR SURGICAL COMPLICATIONS

LABORATORY DIAGNOSIS OF TYPHOID 1. Microbiological procedures 2. Serological procedures 3. New diagnostic tests

1 - Microbiological procedure Bacteremia occurs early in the disease Blood Cultures are positive in 1 st week in 90% 2 nd week in 75% 3 rd week in 60% 4 th week and later in 25%
Salmonella on Mac Conkey's agar

Wilson and Blair bismuth sulphite medium jet black colony with a metallic sheen

2 - SEROLOGICAL PR FELIX-WIDAL T Significant Titers helps in Diagnosis • Serum agglutinins raise abruptly during the 2 nd or 3 rd week • Following Titers of antibodies against the antigens are significant when single sample is tested O > 1 in 160 H > 1 in 320 • Testing a paired sample (7 -10 days) for raise of antibodies carries a greater significance Limitations of Widal test Classically, a four-fold rise of antibody in paired sera Widal test is considered diagnostic of typhoid fever. However, paired sera are often difficult to obtain and specific chemotherapy has to be instituted on the basis of a single Widal test. Furthermore, in areas where fever due to infectious causes is a common occurrence the possibility exists that false positive reactions may occur as a result of non-typhoid

3 - NEW DIAGNOSTIC TESTS • IDL Tubex detects Ig. M 09 antibodies with in few minutes • Typhidot test that detects presence of Ig. M and Ig. G in one hour (sensitivity>95%, Specificity 75%) • Typhidot-M, that detects Ig. M only (sensitivity 90% and specificity 93%) • Typhidot rapid (sensitivity 85% and Specificity 99%) is a rapid 15 minute immunochromatographic test to detect Ig. M. • Ig. M dipstick test

Diagnosis of Carriers Useful in public health purpose. Useful in screening food handlers, cooks, to detect carrier state Typhoid bacilli can be isolated from feces or from bile aspirates Detection of Vi agglutinins in the Blood can be determinant of carrier state.

Misdiagnosis Paratyphoid fever- similar to typhoid fever but usually less severe. Paraenteric fever- a typhoid-like fever but not caused by Salmonella. Gastroenteritis- mild case of typhoid fever may be mistaken for gastroenteritis. Typhomalarial fever Brucellosis Tuberculosis Infective endocarditis Q fever Rickettsial infections Acute diarrhea (type of Diarrhea) Viral Hepatitis Lymphoma Adult Still's disease Malaria

CONTROL OF TYPHOID FEVER 1. Control of reservoirs - cases & carriers 2. Control of sanitation 3. immunization

CASES I. III. IV. V. Early diagnosis by culture of blood & stool Notification done where it is mandatory Isolation till 3 negative tests Treatment by appropriate antibiotics Disinfection of stool & urine by 5% cresol for 2 hours and cloths by 2% chlorine VI. Follow-up examination of stool & urine at 3 -4 months & at 12 months after discharge

Management of typhoid fever: General: Supportive care includes Maintenance of adequate hydration. Antipyretics. Appropriate nutrition. Specific: Antimicrobial therapy is the mainstay treatment. Chloramphenicol, Ampicillin, Amoxicillin, Trimethoprim & Sulphamethoxazole, Fluroquinolones In case of quinolone resistance – Azithromycin, 3 rd generation cephalosporins (ceftriaxone)

Treatment of typhoid fever OPTIMAL THERAPY Susceptibility Antibiotic Fully sensitive Fluoroquinilone Cipro/oflox ALTERNATIVEEFFECTIVEDRUGS Daily dose mg/k g Days Antibiotic Daily dose mg/k g Days 15 5 -7 Chloramphenicol Amoxicillin TMP-SMX 50 -75 75 -100 8 -40 14 -21 14 14 Multidrug resistance Fluoroquinilone Or Cefixime 15 15 -20 5 -7 7 -14 Azithromycin Cefixime 8 -10 15 -20 7 7 -14 Quinolone resistance Azithromycin Or Ceftriaxone 8 -10 75 7 10 -14 Cefixime 20 7 -14 K. PARK

MDR-area OCCATIONAL MDR-area MEDICATION TREATMENT WHO RECOMMENDATIONS

Diet Fluids and electrolytes should be monitored and replaced diligently. Oral nutrition with a soft digestible diet is preferable in the absence of abdominal distension or ileus. Activity No specific limitations on activity are indicated. Rest is helpful, but mobility should be maintained if tolerable. The patient should be encouraged to stay home from work until recovery.

CARRIERS • Identification by culture & serological examination. • Treatment by intensive course of ampicillin/amoxicillin with probenecid for 6 weeks. • Surgery like cholecystectomy if needed. • Kept under surveillance. • Health education.

2 - CONTROL OF SANITATION • Protection & purification of drinking water supplies • Improvement of basic sanitation • Promotion of food hygiene

Best prevention Scrubofthem Scrub themoff offyourhands

Simple hand hygiene and washing can reduce several cases of Typhoid

3 - IMMUNIZATION Vaccination recommended to 1 those live in endemic area 2 household contacts 3 Group at risk like school children and hospital staff etc. 4 - those attending melas & yatras Three types of vaccines 1. Injectable Typhoid vaccine (TYPHIM –Vi, TYPHIVAX) 2. The live oral vaccine (TYPHORAL) 3. TAB vaccine

Injectable Typhim –Vi Vaccine 1. This single-dose injectable typhoid vaccine, from the bacterial capsule of S. typhi strain of Ty 21 a. 2. This vaccine is recommended for use in children over 2 years of age. 3. Sub-cutaneous or intramuscular injection 4. Efficacy : 64% -72%

Typhoral Vaccine 1. This is a live-attenuated-bacteria vaccine manufactured from the Ty 21 a strain of S. typhi. 2. The efficacy rate of the oral typhoid vaccine ranges from 50 -80% 3. Not recommended for use in children younger than 6 years of age. 4. The course consists of one capsule orally, taken an hour before food with a glass of water or milk (1 stday, 3 rd day & 5 th day) 5. No antibiotic should be taken during this period 6. Immunity starts 2 -3 weeks after administration and lasts for 3 years 7. A booster dose after 3 years

Facts of Vaccines for Typhoid Immunity lasts for 3 years Need a booster Vaccines are not effective in prevention of Paratyphoid fevers

Ty 21 a—Oral live attenuated vaccine

Vi-CPS— parenteral vaccine

TH A N K Y O U